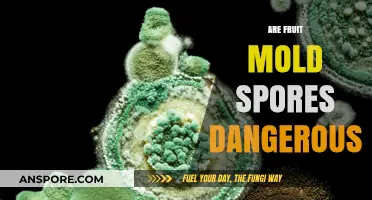
Fruit Mold Spores: Uncovering the Hidden Dangers in Your Kitchen

Glomeromycota, a phylum of fungi primarily known for their symbiotic relationships with plant roots in arbuscular mycorrhizae, presents an intriguing question regarding the nature of their spores. These fungi are characterized by their inability to produce fruiting bodies and their reliance on asexual spores for reproduction. The spores of Glomeromycota are typically unicellular, containing a single nucleus and serving as the primary means of dispersal and survival in adverse conditions. However, recent studies have explored whether certain developmental stages or structures within these spores might exhibit multicellular traits, challenging traditional classifications. Understanding whether Glomeromycota spores are strictly unicellular or if they possess multicellular characteristics is crucial for unraveling their evolutionary biology and ecological roles in soil ecosystems.
| Characteristics | Values |
|---|---|
| Multicellularity of Spores | No, Glomeromycota spores are unicellular. |
| Spore Structure | Spores are typically thick-walled and resistant to degradation. |
| Function of Spores | Serve as survival structures in adverse environmental conditions. |
| Mode of Reproduction | Spores are produced asexually through sporulation. |
| Role in Symbiosis | Spores play a role in colonizing new hosts for arbuscular mycorrhizal symbiosis. |
| Size of Spores | Generally large (20–500 μm in diameter). |
| Shape of Spores | Spherical to irregular shapes. |
| Cellular Content | Contain storage compounds like lipids and glycogen. |
| Dispersal Mechanism | Dispersed through soil, water, or animal vectors. |
| Taxonomic Group | Belong to the Fungi kingdom, Glomeromycota phylum. |
| Ecological Importance | Crucial for plant nutrient uptake (e.g., phosphorus) in ecosystems. |
Explore related products
What You'll Learn

Glomeromycota spore structure: unicellular or multicellular?
Glomeromycota spores are fundamentally unicellular structures, a fact that distinguishes them from the multicellular spores of some other fungal groups. Each spore is a single cell encased in a protective wall, designed to withstand environmental stresses and facilitate dispersal. This unicellular nature is a key adaptation for their role as symbiotic partners with plant roots, enabling efficient colonization and nutrient exchange. Unlike multicellular spores, which may contain multiple nuclei or specialized cell types, Glomeromycota spores are structurally simple, housing a single nucleus and the essential cytoplasmic components needed for germination.
To understand why Glomeromycota spores remain unicellular, consider their ecological niche. These fungi form arbuscular mycorrhizae, intimate associations with plant roots that require rapid and targeted growth. A unicellular spore can germinate quickly, extending hyphae directly into the root system without the need for complex multicellular coordination. This efficiency is critical for establishing symbiosis before competing microorganisms or environmental factors interfere. Multicellular spores, while advantageous in other contexts, would introduce unnecessary complexity and delay in this specific symbiotic relationship.
From a practical standpoint, the unicellular structure of Glomeromycota spores has implications for their use in agriculture and soil restoration. When applying spore-based inoculants to enhance plant growth, understanding their unicellular nature helps optimize conditions for germination. For instance, ensuring adequate soil moisture and temperature is crucial, as these factors directly influence the single-celled spore’s ability to activate and grow. Multicellular spores might require additional cues or resources to coordinate germination, but Glomeromycota spores respond more straightforwardly to environmental triggers.
Comparatively, the unicellular design of Glomeromycota spores contrasts with the multicellular spores of fungi like Basidiomycota, which produce complex structures like basidiospores. While multicellular spores can offer advantages such as increased resilience or specialized functions, Glomeromycota’s unicellular approach aligns with their specific ecological role. This simplicity is not a limitation but a strategic adaptation, allowing them to thrive in their symbiotic niche. For researchers and practitioners, recognizing this distinction is essential for effective study and application of these fungi in various fields.
In conclusion, the unicellular structure of Glomeromycota spores is a defining feature that reflects their evolutionary and ecological specialization. This simplicity enables rapid germination and efficient symbiosis with plant roots, making it a key trait for their success. Whether in scientific research or agricultural practice, understanding this unicellular nature provides valuable insights into how these fungi function and how best to utilize them. While multicellularity has its merits in other fungal groups, for Glomeromycota, unicellularity is the cornerstone of their unique biology.
Lysol's Effectiveness: Can It Eliminate Ringworm Spores Effectively?
You may want to see also

Evidence for multicellularity in Glomeromycota spores
Glomeromycota spores have long been a subject of debate regarding their cellular composition. Recent studies suggest that these spores exhibit characteristics consistent with multicellularity, challenging traditional views of their structure. For instance, electron microscopy has revealed distinct cellular layers within the spore wall, each with specialized functions, such as protection and nutrient storage. This layered organization is a hallmark of multicellular organisms, where division of labor among cells enhances survival and functionality.
To investigate multicellularity in Glomeromycota spores, researchers employ techniques like confocal microscopy and molecular markers. By staining specific cellular components, scientists have identified nuclei and organelles distributed throughout the spore, indicating multiple cells. For example, DAPI staining highlights numerous nuclei, while fluorescent markers for mitochondria reveal a network of these organelles, further supporting the multicellular hypothesis. These methods provide visual and molecular evidence that challenges the notion of Glomeromycota spores as single-celled entities.
A comparative analysis of Glomeromycota spores with other fungal structures underscores their unique features. Unlike unicellular fungal spores, which typically contain a single nucleus and minimal cytoplasmic organization, Glomeromycota spores display complex internal structures. For instance, the presence of septa-like partitions within the spore suggests cellular boundaries, a feature absent in truly unicellular organisms. This comparison highlights the evolutionary divergence of Glomeromycota and reinforces the argument for their multicellular nature.
Practical implications of understanding Glomeromycota spore multicellularity extend to agriculture and ecology. Multicellular spores may have enhanced resilience to environmental stressors, such as drought or pathogens, due to their specialized cellular functions. Farmers and researchers can leverage this knowledge to optimize mycorrhizal inoculants, improving crop yields and soil health. For example, selecting spore batches with robust multicellular structures could enhance their effectiveness in colonizing plant roots and facilitating nutrient uptake.
In conclusion, evidence for multicellularity in Glomeromycota spores is multifaceted, combining advanced imaging techniques, molecular analysis, and comparative studies. Recognizing these spores as multicellular not only advances our understanding of fungal biology but also has practical applications in sustainable agriculture. As research progresses, further insights into their cellular organization will likely reveal additional complexities, solidifying their unique position in the fungal kingdom.
Are Shroom Spores Illegal? Exploring the Legal Gray Area
You may want to see also

Role of spore complexity in Glomeromycota function
Glomeromycota spores are not multicellular; they are unicellular structures that play a pivotal role in the life cycle and ecological function of these fungi. Despite their unicellular nature, the complexity of these spores is a critical factor in their ability to form symbiotic relationships with plant roots, a process known as arbuscular mycorrhiza. This complexity is not measured by multicellularity but by the intricate internal structures and biochemical mechanisms that enable spore function.
Consider the spore wall, a multilayered structure composed of chitin, melanin, and other polymers. This wall is not merely a protective barrier but a dynamic interface that regulates nutrient exchange and signaling between the fungus and its host plant. For instance, melanin in the spore wall enhances resistance to environmental stresses, such as UV radiation and desiccation, ensuring spore longevity in soil. Practical applications of this knowledge include optimizing soil conditions to preserve spore viability, such as maintaining pH levels between 6.0 and 7.5, which supports melanin stability and function.
The internal organization of Glomeromycota spores further underscores their functional complexity. Spores contain lipid droplets, glycogen reserves, and nuclei, all of which are strategically arranged to facilitate rapid germination and hyphal growth upon encountering a suitable host. Lipid droplets, for example, serve as energy reservoirs, enabling spores to survive in nutrient-poor soils for extended periods. Farmers and agronomists can leverage this by incorporating organic matter rich in phosphorus into soils, as this nutrient is critical for lipid metabolism and spore activation.
Comparatively, the simplicity of spore structure in other fungal groups, such as Ascomycota, highlights the unique adaptations of Glomeromycota. While Ascomycota spores often rely on external conditions for germination, Glomeromycota spores are self-contained units capable of delayed germination, a trait essential for their role in nutrient cycling and plant nutrition. This distinction emphasizes the evolutionary significance of spore complexity in Glomeromycota, which has allowed them to dominate arbuscular mycorrhizal networks in diverse ecosystems.
In conclusion, the complexity of Glomeromycota spores lies in their sophisticated internal organization and biochemical properties, not in multicellularity. Understanding this complexity provides actionable insights for enhancing soil health and plant productivity. For example, crop rotation with mycorrhiza-friendly plants, such as legumes, can stimulate spore production and improve soil structure. By focusing on spore function rather than structure, we can develop targeted strategies to harness the ecological benefits of Glomeromycota in agriculture and ecosystem restoration.
Are All Gram-Positive Bacteria Non-Spore Forming? Unraveling the Myth
You may want to see also
Explore related products

Comparing Glomeromycota spores to other fungal spore types
Glomeromycota spores stand out in the fungal kingdom due to their unique structure and function. Unlike the unicellular spores of Ascomycota and Basidiomycota, which are typically haploid and serve primarily for dispersal, Glomeromycota spores are multicellular and chlamydospores, functioning as survival structures rather than direct reproductive agents. This multicellular nature allows them to store nutrients and withstand harsh environmental conditions, a trait not commonly found in other fungal spore types.
To understand the significance of this difference, consider the role of spores in fungal life cycles. While Ascomycota and Basidiomycota spores are often produced in large quantities for wind dispersal, Glomeromycota spores are fewer in number and remain in the soil, forming symbiotic relationships with plant roots. This contrasts sharply with the transient nature of unicellular spores, which must quickly germinate upon landing in a suitable environment. Glomeromycota spores, by virtue of their multicellularity, can persist for years, ensuring long-term survival and readiness to colonize new root systems.
From a practical standpoint, this distinction has implications for agriculture and soil management. Farmers and gardeners can leverage the resilience of Glomeromycota spores by promoting mycorrhizal associations in their crops. For example, incorporating organic matter rich in these spores into soil can enhance nutrient uptake in plants, particularly phosphorus. Unlike unicellular spores, which may require frequent reintroduction, Glomeromycota spores establish persistent networks that benefit plants over multiple growing seasons.
However, the multicellular nature of Glomeromycota spores also presents challenges. Their larger size and complex structure make them less dispersible than unicellular spores, relying heavily on root growth and soil disturbance for propagation. This limits their natural spread compared to wind-dispersed spores of other fungi. To counteract this, agricultural practices such as reduced tillage and the use of inoculants containing Glomeromycota spores can be employed to ensure their presence in root zones.
In summary, comparing Glomeromycota spores to other fungal spore types highlights their unique multicellular structure and ecological role. While unicellular spores excel in rapid dispersal and germination, Glomeromycota spores prioritize longevity and symbiosis. This comparison underscores the importance of tailoring soil management strategies to the specific traits of these spores, maximizing their benefits in agricultural and natural ecosystems.
Are Dead Mold Spores Dangerous? Uncovering the Hidden Health Risks
You may want to see also

Implications of spore structure for Glomeromycota classification
Glomeromycota spores are predominantly unicellular, a characteristic that has significant implications for their classification. Unlike multicellular spores, which may exhibit complex structures and developmental stages, the unicellular nature of Glomeromycota spores simplifies their morphological analysis. This simplicity, however, does not diminish their taxonomic importance. The spore wall’s thickness, ornamentation, and color are critical features used to distinguish between species and genera. For instance, *Gigaspora* spores are known for their large size and distinctive spiny ornamentation, while *Glomus* spores often have a smoother surface. These structural variations provide a foundation for classification, allowing mycologists to identify and categorize Glomeromycota with precision.
The internal structure of Glomeromycota spores also plays a pivotal role in classification. While the spores are unicellular, their cytoplasmic content and organization can vary significantly. Some spores contain multiple nuclei, a feature that influences their reproductive strategies and, consequently, their taxonomic placement. For example, spores with multiple nuclei may indicate a higher capacity for genetic diversity, which is a key consideration in phylogenetic studies. Additionally, the presence of lipid droplets or storage structures within the spore can differentiate between species adapted to different environmental conditions. These internal features, though less visible than external characteristics, are essential for a comprehensive classification system.
One practical implication of spore structure for Glomeromycota classification is the development of standardized identification protocols. Mycologists often rely on spore morphology as a primary diagnostic tool, especially in the absence of molecular data. By focusing on specific structural traits, such as spore size, shape, and wall composition, researchers can create detailed taxonomic keys. These keys are invaluable for field identification, enabling ecologists and agronomists to quickly assess the presence of specific Glomeromycota species in soil samples. For instance, a spore with a thick, melanized wall is likely to belong to a genus like *Sclerocystis*, which is adapted to harsh environments.
However, the reliance on spore structure for classification is not without challenges. The unicellular nature of Glomeromycota spores limits the number of observable traits, making it difficult to resolve closely related species. In such cases, molecular techniques, such as DNA sequencing, are often necessary to complement morphological analysis. Integrating both approaches provides a more robust classification system, ensuring that taxonomic decisions are based on a combination of structural and genetic data. This dual methodology is particularly important in Glomeromycota, where species boundaries can be ambiguous due to the simplicity of spore morphology.
In conclusion, the spore structure of Glomeromycota, while predominantly unicellular, offers a wealth of information for taxonomic classification. External features like ornamentation and internal characteristics like nuclear organization provide critical distinctions between species. Practical applications, such as the development of identification protocols, highlight the importance of spore morphology in field research. Yet, the limitations of relying solely on structural traits underscore the need for integrative approaches that combine morphology with molecular data. By leveraging both, mycologists can achieve a more accurate and comprehensive classification of this ecologically vital group of fungi.
Does Spore Effectively Work on Grass-Type Pokémon? A Detailed Analysis
You may want to see also
Frequently asked questions
No, Glomeromycota spores are unicellular structures produced by the fungus for reproduction and dispersal.
Yes, Glomeromycota form multicellular structures like hyphae and arbuscules during their symbiotic relationship with plant roots, but their spores remain unicellular.
Glomeromycota spores are single-celled and lack the complex, multicellular structures seen in some other fungal groups, such as those in Basidiomycota or Ascomycota.
No, Glomeromycota spores germinate to form unicellular structures that later develop into multicellular hyphae, but the spores themselves remain single-celled.
Glomeromycota spores are unicellular because they consist of a single cell, even though the fungus as a whole forms multicellular structures like hyphae during its life cycle.